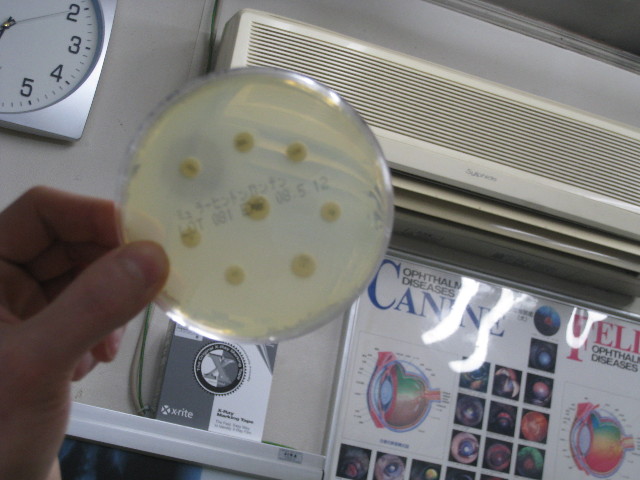
ファイル 638-5.jpg

針検で抜いた液を、早速顕微鏡で調べてくれた。
これは顕微鏡に直接カメラを向けて先生が撮ってくれた画像。
モニタに映し出された画像。
ガンとか悪いものではないとのこと(=´∇`=)....良かった!
液はようするにウミ(膿)
ばい菌とかを攻撃してくれる【白血球】には
・好中球・好酸球・単球・リンパ球・好塩基球とかがあるんだって。
ベベの採取した液には白血球のなかの好中球やマクロファージ?がたくさんらしい。
ようするに、膿んでしまったので、体の中の白血球がやっつけにきてくれているのね。
(でも白血球が増えすぎると良くない)
では、なんでベベちゃんがこんなことになってしまったのか?
原因はいくつか考えられるらしい
・不妊手術の時の糸が残っていてそれがもとで感染した。
(べべは6歳半でうちに帰った来た5年前、訓練学校の獣医さんで不妊手術を受けた)
昔の糸は残る糸(絹糸=安価)が多かった。
今は手術用ナイロン糸(普通・種類によってはかなり高価)や溶ける糸(高価)が多いというか主流?らしい。
ナイロン糸でも撚ってあるのはダメらしい。
・膿皮症になってひっかいたりして外部から感染した。
べべちゃんは10日位前かな?おっぱいのまわりが膿皮症になった
(すぐに治ったけど、そのときにひっかいたのかな?)
等など。
とにかくただの膿だから...なんては言っていられない。
おなかの中からのことだと、腹膜炎になったり骨髄炎になってしまったりすることもあるとのことなので早く治してあげないと!
....それにしてもいつからこんなになっていたんだろう(..)
そんなに前からではないと思うけど、この3〜4日かな??
スタッフが見つけてくれたから良かったけど、ママはちっとも気がついていなくて....ごめんねベベちゃん。
先生に変わった様子はなかったですか?とかきかれて、元気だったとお答えしたけど本当はきっと少し痛かったんだね。。。
本日の治療としては、即効性のある抗生剤の注射。
このお注射、しみるらしいけどベベちゃんよい子にしてくれていたよp(`ー´)q
明日の晩から飲み薬の抗生剤(VICTAS40)を1日1回、1回3.5錠。
で、ベベちゃんから採取した液を培養して、2日後の日曜に正式なお薬を決定するの。
これはほかのワンちゃんのだけど、左端の黄色い粒のまわりが薄くなっているでしょ?
全体的に薄い黄色になっているのは菌が生えているところ。
そこにいくつか置いてある黄色の粒は各種抗生剤(だと思う)
左端の黄色い粒のまわりは、菌が繁殖できなくて白く抜けている。
これが【効果のあるお薬】だってこと。
(もっとスカンときれいに透明に色が抜けるのが良いらしい)
血液検査の結果は赤・白ともに問題なさそう。(でも赤血球容積はいつもより低い)
白血球数は11700で(正常値6000〜17000)思ったほど高くなかった。
内臓系の数値はどれも良かった(^o^)v
もしもお薬が効かなかったら、根本の原因を絶たないとならないということなので、手術してその部分をとることになるって......。
お薬ですっかり良くなりますように!!!
 もにもに成長日記♪...あいばろ〜ず7頭一緒♪
もにもに成長日記♪...あいばろ〜ず7頭一緒♪








